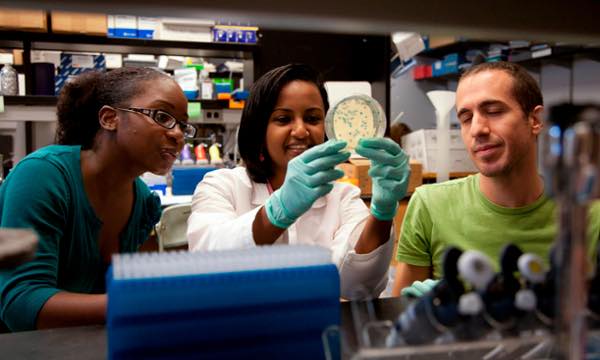

Admission Requirements

Admissions committees consider prior research experience to be the most important factor in the application review process, followed in order by letters of recommendation from research mentors, transcripts and GPA, other relevant letters of recommendation, if any, and honors and/or leadership positions. GRE scores are not required by any of the Programs in the Graduate Division of Biological and Biomedical Sciences. Please refer to each Programs website for additional information regarding the admissions process.
Members of the admissions committees consider all portions of the application when making their decision. We have no set minimums. General requirements include:
- A strong undergraduate background in the physical, biological, or behavioral sciences.
- A cumulative average of B+ or better in major science courses.
- High motivation for a career in biological or biomedical research.
- Strong letters of recommendation (three are required).
- A thoughtfully written Statement of Purpose that includes information on why you want to attend graduate school, any research interests you may have, and details on any prior research experience, including the extent to which you were intellectually and independently involved in your research project. There are no word or page limits, however, we recommend that the statement of purpose be no longer than two pages double-spaced. This is only a recommendation, and your statement of purpose can be longer, if needed.
- GRE scores are not required and there is no field to enter this information in the application.
- International applicants whose native language is not English must also complete the Test of English as a Foreign Language (TOEFL).
- Some programs may have an additional requirement or recommendation for applicants, so you should review the admissions page for the program you are applying to.
Advice from Admissions Directors:
Applying to Graduate School
Additional Information
Additional information on the application process can be found on our Apply page.
If you would like to receive additional information on the Graduate Division of Biological and Biomedical Sciences and its eight programs please complete our inquiry form. We will send you periodic emails with additional information about our programs, Emory, and the Atlanta area.
MD/PhD Program
Students applying to the Medical Scientist MD/PhD Program should have an outstanding academic background in science or mathematics, as well as research experience as undergraduates. Application to the program is accomplished through the American Medical College Application Service (AMCAS) to the Emory University School of Medicine (deadline October 15th). All supplemental materials and letters of recommendation must be received by the Emory Medical School Office of Admissions by December 1. Acceptance into the MD/PhD Program usually occurs prior to entering the first or second year of medical school. Tuition and a competitive yearly stipend are provided for all students accepted into the MD/PhD Program. This program is supported in part by a Medical Scientist Training Program grant from the National Institutes of Health. To learn more about visit the Emory MD/PhD Program website.